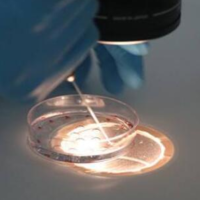

试管
"的相关帖子
一代试管精卵不结合马上能做二代单精子注射补救吗?
问题描述:我和老公因为不孕,之前都去医院做了详细的生育检查确诊了不孕不育,再三考虑之后决定去做一代试管。一开始取了15个卵泡满心欢喜的在等胚胎培育结果,但没想到医生告知精卵不结合,治疗不会很顺利,真的把我们急怀了也不知道该怎么办。今天听别人说可以做二代试管单精子注射补救,想问大家出现不结合马上就能转做其他治疗方式吗?最佳回答:需要在医生检测后再决定能否做二代单精子注射治疗。精卵不结合可以做二代试管...

基因缺陷可以做一代试管来阻断吗?
问题描述:我结婚1年半还没有怀上,去医院检查后发现是输卵管堵塞,然后还有基因问题,我在做之前大概了解了一下,试管有很多代,我想问问这种基因问题缺陷可以做一代试管来阻断吗?最佳回答:不能,一代试管婴儿技术本身并不具备对基因缺陷进行筛查和阻断的能力。它只是将精子和卵子在体外结合,形成受精卵并移植到子宫内,无法对胚胎的基因进行筛选和修改。如果想阻断基因问题,建议做三代试管婴儿,因为三代技术结合了PGT技...
第二次移植试管要重新定促排方案吗?
问题描述:我和老公备孕一直未怀,去医院检查,发现输卵管双侧堵塞导致,就去做了一代试管治疗,后面取卵后,移植失败了,医生让我休息一段时间再进行二次移植,我想问问二次移植要重新定促排方案吗?最佳回答:要看情况,如果有剩余卵子就不需要,但是有时候需要重新制定促排卵方案。这一方案的制定具备个体化特点,取决于第一次移植的结果、患者的身体健康状况及专业医生的建议。为了确保每一步的顺利进行,建议患者与医疗团队保...

试管移植的时候可以不用鸭嘴钳来扩张阴道吗?
问题描述:下周我就要去做胚胎移植手术了,在这之前我在网上了解这个手术的一些操作,看到有人说会使用到鸭嘴钳我就有点担心。因为医生说胚胎移植过程不是很痛,所以我就不想用麻药。但我了解到移植可能会使用到鸭嘴钳来扩张阴道我就有带你害怕,想问问移植的时候可不可以不用这个工具?最佳回答:视情况而定。在胚胎移植前,医生可能会使用鸭嘴钳来评估宫颈和阴道的状况,确保移植过程的顺利进行。然而,这个操作并非必要步骤,具...

大三阳女性可以做一代试管阻断生下健康孩子吗?
问题描述:前段时间我们公司组织一年一度的员工体检,今天我在人事那拿到了我的检查报告。我拿到看了一下,关于乙肝五项的检查中我是大三阳,我现在又要想宝宝,所以想问问可以做一代试管阻断生下健康孩子吗?最佳回答:如果女方有乙肝大三阳,可以做但不建议做试管婴儿,做一代试管是在体外培养胚胎,等胚胎形成后还还是会移植到女性的子宫内,如果成功怀孕,乙肝病毒很有可能就会通过胎盘传染给胎儿,对胎儿的健康来说是不利的,...

第一代试管剩余的胚胎能转第三代移植吗么?
问题描述:我和妻子结婚有五年多了,刚开始不想要孩子,后来备孕一直没有怀上,去医院检查后才知道妻子有子宫内膜异位症一直无法正常怀孕,早些时候去做了一代试管没成功,不过当时取出的受精卵一直在冷冻保存,请问能转第三代移植吗么?最佳回答:不能直接转成三代,原因是一代试管婴儿和三代试管婴儿的适应症不同。做一代试管婴儿发现胚胎质量不好,需要转三代试管,是需要重新调理取卵之后再进行第三代试管婴儿的。第三代试管婴...

在安徽医科大学第一附属医院做试管一般先建档还是先定治疗方案?
问题描述:在决定接受辅助生育治疗之后,我们就开始在网上查找合适的医院。看到有人推荐离我们家很近的安徽医科大学第一附属医院,说医生水平很不错,且有数据显示治疗成功率也不低。因为还没有去做相关检查和准备,因此想问问做试管一般是先建档还是先定治疗方案?最佳回答:试管婴儿的流程是先建档然后再制定治疗方案。面对无法生育的夫妻而言,做试管是实现生育的一种不错方式。虽然治疗会涉及到很多流程,不过进入试管周期后医...

甲状腺良好但过氧化物酶抗体高降不下来会影响试管移植吗?
问题描述:我在做了试管取卵手术后就一直在家里调理身体,因为制定的冻胚移植方案所以我有很长的时间去准备。但昨天去做了移植前检查发现我过氧化物酶抗体高,虽然试管前就查出来我甲状腺没什么问题,但这个数值一直降不下来。眼看马上就要到移植时间了,想了解下这个情况会影响到试管移植吗?最佳回答:会。甲状腺功能正常但高抗体水平可能在妊娠后引起甲状腺功能的波动,这可能导致母体和胎儿的潜在风险。对于做试管治疗的这类女...

不打降调的试管方案是微刺激方案吗?
问题描述:本人今年四十多岁,目前正在做一代试管生二胎,前天刚刚去医院检查完身体,准备明天去医院定方案了,我刚刚查到定方案有很多种,像我这种年龄的女性做试管是不用降调的,所以想问问是微刺激方案吗?最佳回答:不打降调的试管方案并不等同于微刺激方案。实际上,除了微刺激方案外,还有其他几种不需要进行降调的试管方案,例如拮抗剂方案和短方案。具体使用哪种方案,需要根据患者的身体状况、年龄、卵巢功能以及医生的判...

有内膜息肉增生用什么试管方案才能提高受孕率?
问题描述:我才32岁,因为最近有备孕计划所以去做了生育检查后却被告知我有内膜息肉,再加上卵巢功能不是很好所以结合多种因素考虑后医生建议我们做试管治疗。了解到有多种试管方案,我特别担心治疗后效果不是很好,所以想问问用什么方案能提高受孕率?最佳回答:需要结合具体情况来制定个性化试管方案。子宫息肉是一种常见的子宫内膜异常增生疾病,虽然是无症状的但也可能导致不孕不育问题的发生。针对不同程度的息肉,医生也会...

试管第一代婴儿取出来的卵子全部无法受精是怎么回事呢?
问题描述:我结婚后怀孕生化过两次,做了一次宫腔镜手术来消除卵巢囊肿,那时我也不明白为什么会生化,只是想尽快怀孕,还来才发现我有囊肿和子宫内膜异位症,所以就去医院做了一代试管,但是取出来的卵子全部无法受精是怎么回事呢?最佳回答:试管第一代婴儿取出的卵子全部无法受精的原因可能涉及精子、卵子、实验室以及其他多个方面。如果遇到这样的情况,建议与专业的生育医生进行详细沟通,进行全面评估与分析,以确定原因并制...

35岁以上大龄做试管二代会比一代成胚率更高吗?
问题描述:这个月结束我就是37岁了,因为结婚比较晚所以现在还没有生育。不过,我们也试过备孕,但身体原因一直没有怀上所以做了检查后决定去做试管治疗。不过,我目前在纠结做一代还是二代,有人说大龄女性做试管技术选择会影响成胚率,所以我想问问我做二代会比做一代成胚率更高吗?最佳回答:不一定。试管成胚率和精卵质量以及个人身体素质有很大关系。单从试管技术来看,一代试管是传统的I体外受精治疗技术,而第二代”指的...

女性年龄小做试管婴儿有优势吗,具体有哪些呢?
问题描述:我知道35岁之后生孩子比较难,也会面临很多危险。所以想早点生娃,我老公也是比较支持我的。我是准备直接去医院做试管婴儿的,不过在做术前检查的时候有点输卵管堵塞,所以想问问年龄小做试管婴儿有优势吗,具体有哪些呢?最佳回答:女性年龄小在做试管婴儿时具有显著的生理、心理以及生活习惯等方面的优势。然而,每个人的情况都是独特的,具体成功率还需根据个人实际情况进行评估。因此,在选择试管婴儿技术时,患者...

试管适时适量GN是什么促排方案,适合哪种人群?
问题描述:昨天改了试管医生的号去做了试管咨询和一些初步检查,在拿到报告和结合我们的备孕描述,建议我们促排时采取适时适量GN方案来进行。但我之前更多的听过短方案和长方案这种,想问问这是什么方案,适合哪种人群?最佳回答:试管适时适量GN方案是GnRH拮抗剂,这种治疗方式主要使用GnRH拮抗剂来控制卵泡的发育和排卵,从而提高受孕机会。这种促排方案主要适用于年龄较大或者卵巢反应性较差的女性,不过每个人身体...

试管婴儿移植初期出淡淡的血肚子有点胀痛正常吗?
问题描述:我结婚3年多了都没有怀孕,我其实自己是比较担心的,因为害怕是自己的原因造成的不孕,所以就一直没有去做检查。现在年龄大了,一直又没有孩子就还是和老公一起去医院检查了,才发现我的输卵管伞端堵塞,迫不得已和老公做了试管婴儿,在移植后的第十天我上厕所发现有点出血淡淡的,还有点胀痛,是正常的吗?最佳回答:大多数情况下这些症状是正常的,移植后胚胎着床过程中可能会引起少量出血,这通常是着床出血,一般出...

o型血抗体成阳性能做试管婴儿生育健康的宝宝吗?
问题描述:我是O型血,在结婚之前就听说我这个血型最后是找同样血型的,怀孕后对宝宝也比较好。巧的是和我老公同样也是这个血型,因此我们就很放心在备孕。然而,在备孕半年左右多没有怀上,在去做了生育检查后确定我身体无法自然怀孕就建议做试管。但我偶然间看到我抽血检查提示抗体阳性,想问问这个情况下做试管能生育出健康的宝宝吗?最佳回答:可以。O型血阳性是指在血液中既不含A抗原,又不含B抗原的血型。对于这类女性而...

试管超长方案促排有什么优缺点,有人能说下吗?
问题描述:我因为患有子宫腺肌症,备孕很长一段时间都没能成功,所以我选择了做试管婴儿,昨天刚刚完成了术前检查。医生让我明天去医院定促排方案,我之前做攻略看别人说超长方案的成功率是非常高的,因此想问问超长方案促排有什么优缺点呢?最佳回答:试管超长方案促排具有卵子数量多、抑制病灶、可控性高和预防遗传病等优点,但同时也存在周期过长、舒适度差、费用较高和潜在风险等缺点。在选择促排方案时,患者应充分了解各种方...

做试管HLA抗体1是阳性能移植鲜胚吗?
问题描述:我今年已经33岁了,因为不能自然怀孕,所以选择了做试管婴儿,但是做检查的时候发现HLA抗体1,是阳性,我现在有点担心后续的治疗,我本来打算移植鲜胚的,所以想问问这样情况还能移植鲜胚吗?最佳回答:HLA抗体1阳性对于试管婴儿中鲜胚的移植确实可能产生一定影响,但并不意味着绝对不能进行移植。通过免疫抑制剂治疗、选择合适的移植时机以及加强监测和随访等措施,可以提高移植的成功率并减少并发症的风险。...

宫腔粘连和多囊患者做试管选促排方案区别有哪些?
问题描述:我两年前自然受孕怀上过一次胎停了,之后就一直没怀上,由于我比较胖,月经也不正常,所以怀疑是多囊,检查果然是多囊,我朋友是宫腔粘连,我们两个都打算做试管,所以想问问这两种情况做试管选促排方案区别有哪些呢?最佳回答:区别主要体现在患者的具体病情、促排方案的选择原则以及检测频率的具体实施上。因此,在制定促排方案时,医生需要根据患者的具体情况进行综合考虑,以制定出最适合患者的个性化治疗方案。宫腔...

试管一代囊胚能筛出染色体异常的胚胎吗?
问题描述:我之前怀过一个孩子,后面就自然流产了,目前快备孕一年了,也没有好消息,现在准备做一代试管婴儿,移植的是一枚优质囊胚,我怕我老公精子质量不好导致染色体异常,所以想问问囊胚能筛出染色体异常的胚胎吗?最佳回答:可以,试管一代囊胚的染色体筛查通常采用PGS技术。PGT-A技术利用取自囊胚细胞的样本进行检测,以确定其携带的染色体是否正常。在实验室环境中,专业人员将取样后的细胞送往基因检测机构进行分...
-
润康几个月吃对胎儿最好?抓住这三个营养关键期
 3
3
-
广州生殖医院哪家最好的医院,8家实力机构助你圆梦
 5
5
-
育儿假怎么休,一文教你如何顺利申请
 5
5
-
吃完海鲜千万别碰5种食物,科学解读助你吃得安心又健康
 6
6
-
叶黄素真的可以治疗近视吗?一文揭开营养补充剂的护眼真相
 4
4
-
送初生婴儿礼物排行榜,这10件实用又走心的选择准没错
 4
4
-
两个孕囊一大一小是龙凤胎吗?揭开超声背后的科学真相
 6
6
-
西安生殖科排名前十的医院,这份综合指南帮你精准选择
 5
5
-
孕前检查免费和自费区别,这份避坑指南让你钱花在刀刃上
 5
5
-
已婚女性梦见怀孕是喜是忧?揭秘背后预兆与心理真相
 29
29
-
我最近在考虑禁欲,不知道对女生来说有什么好处和坏处?
 14
14
-
我婆婆老说看孕妇肚子形状就能知道男女,这个说法靠谱吗?
 11
11
-
我听说怀男孩早期会有一些特别的感觉,这是真的吗?
 36
36
-
我最近备孕,听说有些特征能看出受精卵着床了?
 37
37
-
我想买早孕试纸,哪个牌子的最早最准啊?
 32
32
-
我刚怀孕一个月,听说有些方法可以测胎儿性别,是真的吗?
 47
47
-
我还在哺乳期,最近感觉不太对劲,会不会又怀孕了?
 35
35
-
我孩子的体检报告上写着"年生长评价不合格",这是什么意思啊?
 30
30
-
我在网上看到用盐水可以验孕,这种方法靠谱吗?
 22
22
-
听说女人天天吃鸽子蛋特别好,是真的吗?
 30
30
-
50岁去泰国试管婴儿好吗,值不值得去
 7492
7492
-
试管医院一般周六日的医生靠谱吗
 7666
7666
-
试管失败医院有责任吗,试管失败责任在谁
 7908
7908
-
囊胚4bc几乎是女孩,有事实依据吗?
 5465
5465
-
卖精子合法吗,供精试管的精子买的吗
 7517
7517
-
试管怀孕八个月还能上班吗,是不是可以休产假了?
 8573
8573
-
囊胚bc级什么意思,质量好与坏?
 5578
5578
-
试管823胚胎什么意思,是哪种等级的胚胎?
 5148
5148
-
治疗子宫肌瘤才能做试管婴儿吗,医生怎么说
 5674
5674
-
试管怀孕能吃辣椒吗?怀孕后是否要忌辣?
 4623
4623






